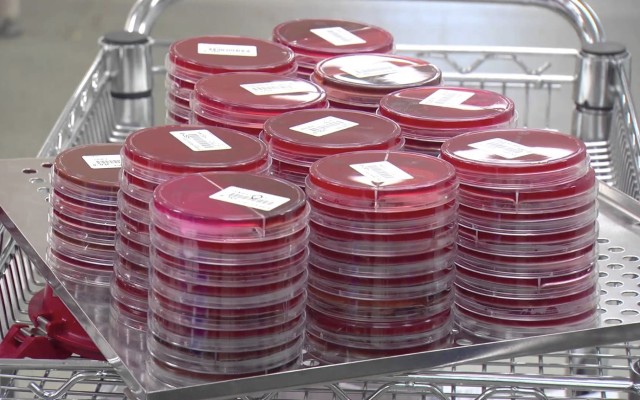
LBT Innovations completes first sale of APAS Independence

LBT Innovations (ASX: LBT) has announced the first sale of the company’s Automated Plate Assessment System (APAS) Independence instrument to a major hospital.
Earlier today, the medical technology company said it had secured the first commercial sale of its APAS Independence system to St Vincent’s Hospital in Melbourne, after successfully completing a six-week independent evaluation using a pre-production instrument last year.
The evaluation was the first in-situ installation of the instrument globally and provided “clear validation” that the foundational technology works by delivering efficiencies in a laboratory, according to LBT CEO Mr Barnes.
The APAS instrument is based upon LBT’s intelligent imaging and machine learning software, and remains the only US FDA-cleared artificial intelligence technology for automated imaging, analysis and interpretation of laboratory samples.
Looking into APAS Independence
APAS utilises artificial intelligence to automate imaging, analysis, interpretation and reporting of growth on microbiology plates after incubation.
According to LBT, the APAS Independence instrument is about the size of a large photocopier, improves the diagnostic efficiency of microbiology laboratories and enables faster reporting of infectious diseases.
With the trial now successfully completed, the first purchase order has now been placed with LBT as the appointed distributor for Australia and New Zealand. There is a “commercial-ready production version” of the APAS Independence already installed at St Vincent’s, making it the world’s first hospital to implement APAS as a screening tool.
LBT has chosen to keep the commercial terms undisclosed and says that “the sale price is consistent with anticipated market pricing previously disclosed with further detail of the payment terms remaining commercial in confidence.”
It is expected that LBT will generate revenue directly as the Australian distributor of the instrument, in addition to the revenue generated by Clever Culture Systems (CCS), a 50% owned joint venture company. CCS is the supplier of the instrument and associated analysis modules, as well as being responsible for managing the “regulatory pathway”.
Clearing regulatory hurdles
The deal between LBT and St Vincent’s means APAS will be deployed in a clinical “real world” environment and will thereby be subject to a stringent regulatory process.
For APAS to be effective, it must meet all regulatory guidelines including demonstrating the clinical performance of each new analysis module through analytical and performance testing.
According to LBT, following an evaluation of a number of potential service providers, St Vincent’s Hospital was selected to provide these analytical and performance testing services to CCS.
Furthermore, as a result of the six-week trial period, St Vincent’s Hospital has been selected given its familiarity with the instrument and its ability to act as a “centre of excellence” for other potential customers and physicians to observe the instrument in a commercial setting.
“We are proud to deliver the first sale of an APAS Independence instrument globally in our launch market of Australia. We have been working for the past five years to deliver this important milestone. The decision by St Vincent’s Hospital to purchase an instrument provides validation for our APAS technology and we look forward to continuing to collaborate with St Vincent’s Hospital in the development of future analysis modules and as a centre of excellence,” said Brent Barnes, managing director and CEO of LBT Innovations.
He added that “we know our shareholders have been waiting for this news for some time and we are committed to achieving other instrument placements in 2018.”
News of the LBT’s first commercial sale of APAs Independence pushed its share price up to $0.135 per share this morning, up around 18% on the day.